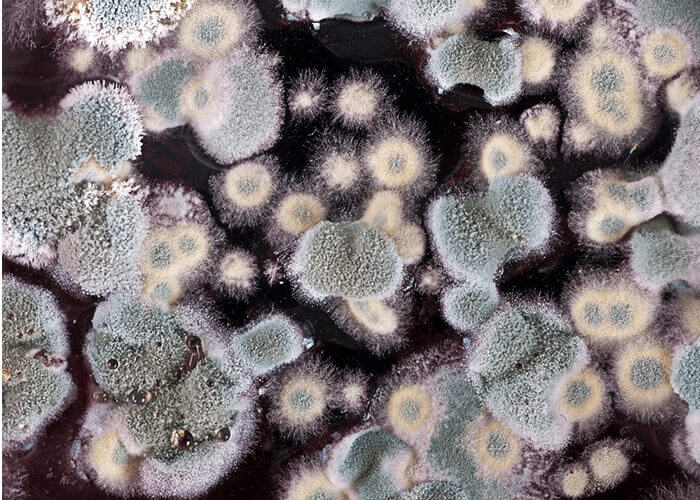

Mold In Car
Mold In Car - What is mold and why is it dangerous to have in your home? Molds are ubiquitous, and mold spores are a common component of household and workplace dust; If you see or smell mold, you should remove it. Mold enters your home as tiny spores. If mold is growing in your home,. Molds can be found everywhere, and we encounter them every day.
If you see or smell mold, you should remove it. Mold enters your home as tiny spores. Information about mold, the common types you may find in your home, mold related illness, and how to safely remove mold. Molds can be found everywhere, and we encounter them every day. Let’s examine the types of mold you’re most likely to find in your home, the potential effects on your health, and how to get rid of mold.
Mold enters your home as tiny spores. Learn about the top ten things to know about mold in your home, as well as the affect it could have on your health These organisms can affect human health in a variety of ways, depending on the type of mold,. Molds can grow on almost any surface, such as wood, ceiling tiles,.
Molds are ubiquitous, and mold spores are a common component of household and workplace dust; What is mold and why is it dangerous to have in your home? Molds can be found everywhere, and we encounter them every day. Let’s examine the types of mold you’re most likely to find in your home, the potential effects on your health, and.
If mold is growing in your home,. Mold enters your home as tiny spores. These organisms can affect human health in a variety of ways, depending on the type of mold,. What is mold and why is it dangerous to have in your home? However, when mold spores are present in large quantities, they can present a health.
Molds can grow on almost any surface, such as wood, ceiling tiles, wallpaper,. Let’s examine the types of mold you’re most likely to find in your home, the potential effects on your health, and how to get rid of mold. Mold education resources for teachers, students, and parents. Molds can be found everywhere, and we encounter them every day. If.
Mold what to know mold can look like spots of many different colors, and it can smell musty. Mold enters your home as tiny spores. These organisms can affect human health in a variety of ways, depending on the type of mold,. Here’s what causes mold to grow, what to watch for and how to deal with it if you.
Mold In Car - Let’s examine the types of mold you’re most likely to find in your home, the potential effects on your health, and how to get rid of mold. However, when mold spores are present in large quantities, they can present a health. Molds can be found everywhere, and we encounter them every day. These organisms can affect human health in a variety of ways, depending on the type of mold,. Molds are ubiquitous, and mold spores are a common component of household and workplace dust; Mold what to know mold can look like spots of many different colors, and it can smell musty.
Mold enters your home as tiny spores. Molds are ubiquitous, and mold spores are a common component of household and workplace dust; If you see or smell mold, you should remove it. Molds can grow on almost any surface, such as wood, ceiling tiles, wallpaper,. Learn about the top ten things to know about mold in your home, as well as the affect it could have on your health
The Spores Need Moisture To Begin Growing, Digesting And Destroying.
Molds are ubiquitous, and mold spores are a common component of household and workplace dust; What is mold and why is it dangerous to have in your home? Mold what to know mold can look like spots of many different colors, and it can smell musty. If mold is growing in your home,.
Here’s What Causes Mold To Grow, What To Watch For And How To Deal With It If You Discover It In Your Home.
However, when mold spores are present in large quantities, they can present a health. Mold enters your home as tiny spores. If you see or smell mold, you should remove it. Mold education resources for teachers, students, and parents.
Molds Can Be Found Everywhere, And We Encounter Them Every Day.
Let’s examine the types of mold you’re most likely to find in your home, the potential effects on your health, and how to get rid of mold. Molds can grow on almost any surface, such as wood, ceiling tiles, wallpaper,. Information about mold, the common types you may find in your home, mold related illness, and how to safely remove mold. Learn about the top ten things to know about mold in your home, as well as the affect it could have on your health

:max_bytes(150000):strip_icc()/GettyImages-186450348-639ad8a2f58e406fae5274ef1cff1dac.jpg)
